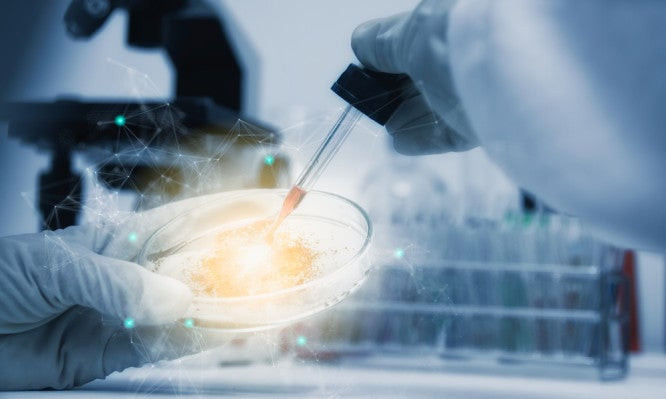
Γεγονός τα πρώτα λειτουργικά βλαστοκύτταρα εργαστηρίου – Άλμα στην θεραπεία της λευχαιμίας

ΕΠΙΣΤΗΜΗ
-

Το μυστήριο του «ματωμένου καταρράκτη» – Οι επιστήμονες βρήκαν την εξήγηση (εικόνες)
Το 1911 ο βρετανός γεω-επιστήμονας Thomas Griffith Taylor ανακάλυψε ένα μέρος πολύ ιδιαίτερο στην Ανταρκτική. Από καιρό σε καιρό κόκκινο νερό έσταζε κατά μήκος ενός παγόβουνου, και καν...
Read More » -

Ανακαλύφθηκαν 40 νέα γονίδια που σχετίζονται με την ανθρώπινη νοημοσύνη
Οι επιστήμονες ανακάλυψαν 40 νέα γονίδια που σχετίζονται με την ανθρώπινη νοημοσύνη, ανεβάζοντας σε 52 τον συνολικό αριθμό που έχει ανακαλυφθεί έως σήμερα. Η ανακάλυψη μπορεί να φωτίσει ...
Read More » -

Νέα έρευνα: Ο πρώτος άνθρωπος εμφανίστηκε, πιθανώς, στην Ελλάδα (εικόνες)
Μέχρι σήμερα πιστεύαμε ότι η εξέλιξη του ανθρώπινου είδους ξεκίνησε στην Αφρική. Ωστόσο σύμφωνα με νέα γερμανική έρευνα ο πρώτος άνθρωπος μπορεί να είχε εμφανιστεί στα Βαλκάνια, ίσως στη...
Read More » -

Νέα μέθοδος μετατρέπει τα ξύλα σε βιοκαύσιμα και χημικά
Επιστήμονες στις ΗΠΑ -μεταξύ των οποίων ένας Έλληνας χημικός μηχανικός- ανακάλυψαν την πιο αποτελεσματική έως σήμερα μέθοδο για να μετατρέπουν τα ξύλα και τη λοιπή μη εδώδιμη βιομάζα των...
Read More » -

Ψυχρό Σημείο: Επιστήμονες ίσως βρήκαν την πρώτη απόδειξη περί ύπαρξης παράλληλων συμπάντων (βίντεο)
Ο όρος «πολυσύμπαν» (multiverse) χρησιμοποιείται για να περιγράψει την ύπαρξη άπειρων παράλληλων συμπάντων, τα οποία (συν)υπάρχουν σε άλλες διαστάσεις, χωρίς να γίνονται αντιληπτά από εμ...
Read More » -

Για πρώτη φορά αναπαρήγαγαν στο εργαστήριο την επικίνδυνη διαστημική ακτινοβολία – Συμμετείχε και Έλληνας επιστήμονας
Επιστήμονες από τη Βρετανία (μεταξύ των οποίων ένας Έλληνας ερευνητής), τη Γερμανία και τις ΗΠΑ ανέπτυξαν μια συσκευή που μπορεί να αναπαράγει στο εργαστήριο την επικίνδυνη ακτινοβολία τ...
Read More » -
Γεγονός τα πρώτα λειτουργικά βλαστοκύτταρα εργαστηρίου – Άλμα στην θεραπεία της λευχαιμίας
Δύο επιστημονικές ομάδες, ακολουθώντας διαφορετικές τεχνικές, δημιούργησαν για πρώτη φορά στο εργαστήριο βλαστοκύτταρα που παράγουν το αίμα. Ανοίγει έτσι ο δρόμος για τη δημιουργία εργ...
Read More » -

Δημιουργήθηκε το λεπτότερο ολόγραμμα στον κόσμο – Έχει πάχος μόλις 25 νανομέτρων
Το πιο λεπτό ολόγραμμα στον κόσμο δημιούργησαν ερευνητές από την Αυστραλία και την Κίνα, ανοίγοντας το δρόμο για την ενσωμάτωση της τρισδιάστατης ολογραφίας στις καθημερινές ηλεκτρονικές...
Read More » -

«Καμπανάκι» από τους επιστήμονες – Θέμα χρόνου ένας υπερ-σεισμός στην Κωνσταντινούπολη
Οι επιστήμονες θεωρούν θέμα χρόνου πότε θα πλήξει την Κωνσταντινούπολη ένας νέος μεγάλος σεισμός, πιθανού μεγέθους επτά βαθμών ή και μεγαλύτερος. Μια νέα μελέτη Γερμανών επιστημόνων εκτι...
Read More » -

Βρέθηκε εξωπλανήτης που μπορεί να έχει ατμόσφαιρα άρα και ζωή!
Ορισμένοι -ιδίως ο ένας- από τους επτά «γήινους» εξωπλανήτες, που περιφέρονται γύρω από το κοντινό άστρο Trappist-1 και οι οποίοι ανακαλύφθηκαν φέτος το Φεβρουάριο, είναι πιθανό να διαθέ...
Read More »
